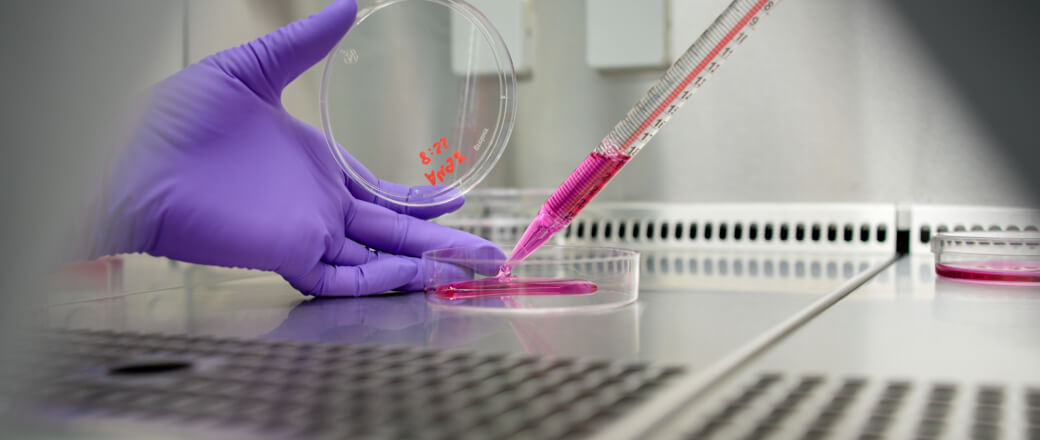

Explore All Modalities
We offer support for the development of a broad range of therapeutic modalities.
Thanks to our extensive service portfolio, we can support you from the early stages of target discovery and validation through high-throughput screening and into preclinical research and characterization. We have experience collaborating with clients to develop novel next-generation therapeutics, as well as established modalities. Beyond our screening services, which focus on small-molecule drug discovery, our proteomic and chemoproteomic technologies can advance the development of virtually any therapeutic class.
Services
Explore how our services can support your drug modality of choice
Submit a Project Inquiry
To connect with our scientific team, submit a project inquiry. Our team will be in touch shortly to schedule an introductory meeting.

Locations